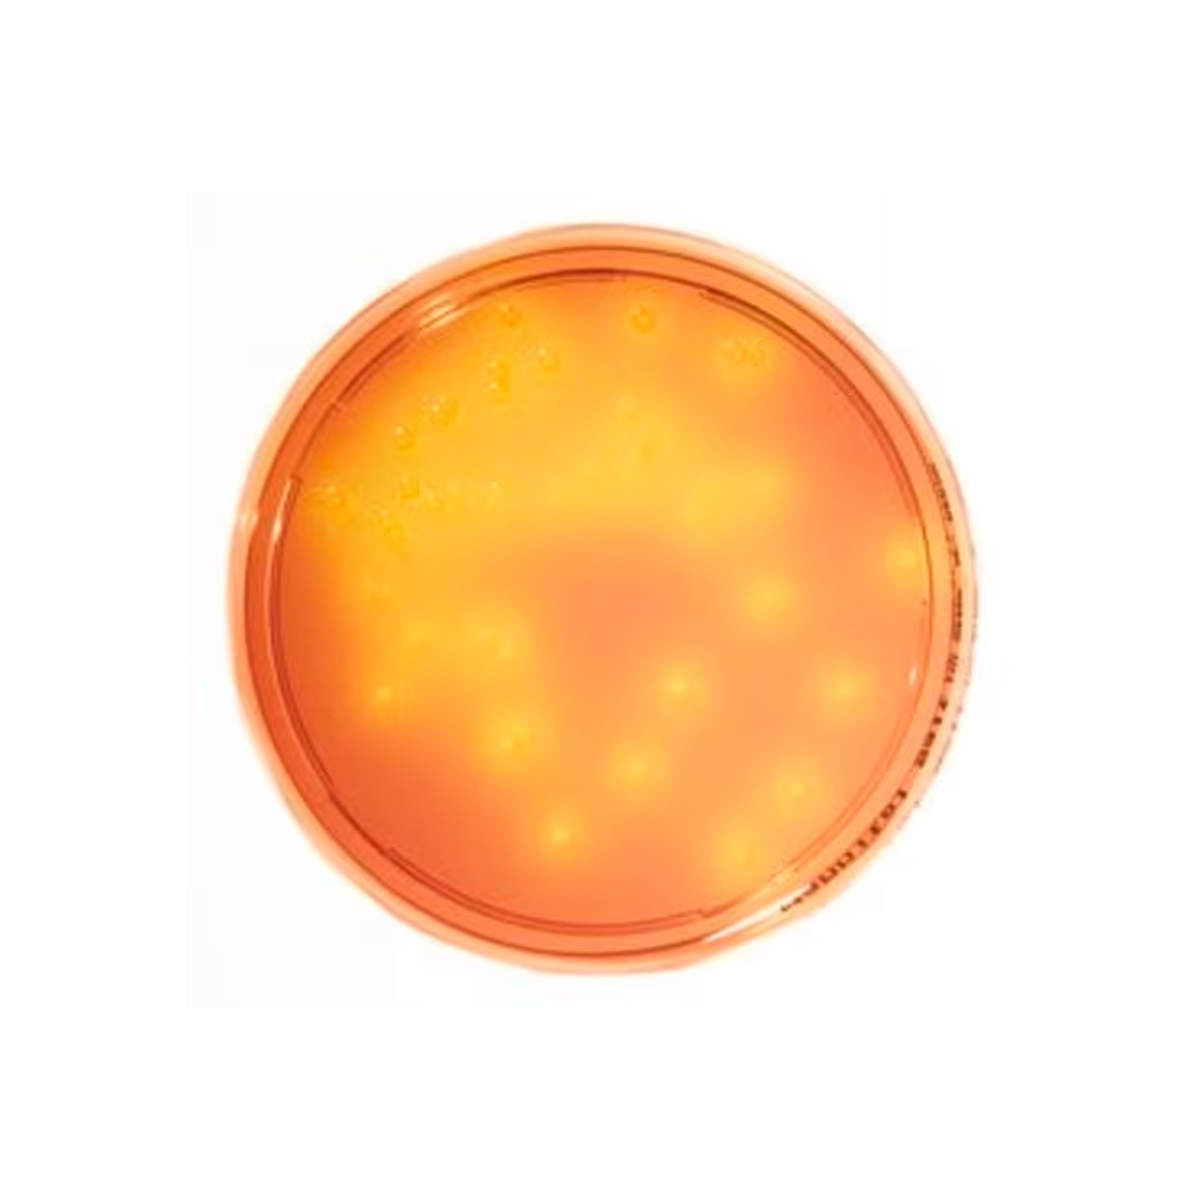

1
/
of
1
SKU:1460230020
Merck
HEIMPLATE Mannitol Salt Agar
HEIMPLATE Mannitol Salt Agar
Temporarily out of stock or special order item. Our customer service will provide a delivery estimate.
Product description
Product description
Heimplate, plate diam. 90 mm, ICR Settle plate for long incubation in non-sterile pharmaceuticals -, for Staphylococcus spp.
Additional information
Additional information